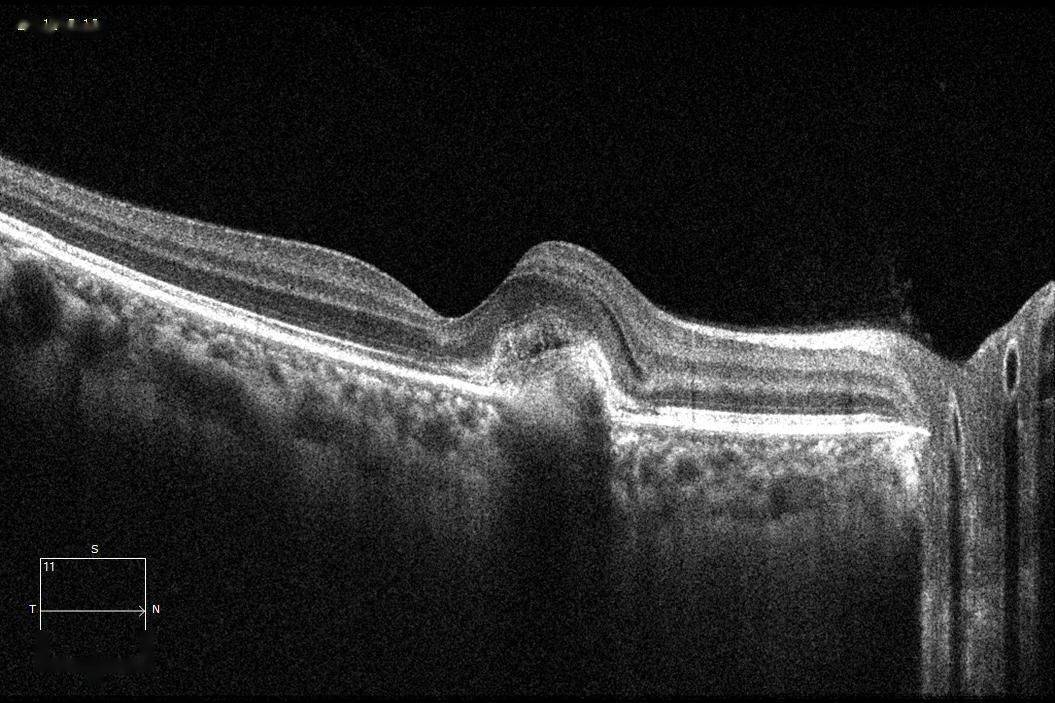
每周最佳病例分享 | 从一个cnv说起

cvte真实

呆呆和你谈谈入职cvte一个月的感受
图片尺寸1080x1440
有谁知道这张图~能说说是什么意思~是脉搏和心跳图吗?
图片尺寸936x1664
cvte北京产业园开园啦!
图片尺寸1728x1080
第一站:参观cvte
图片尺寸2667x2000
cvte实习体验免费自助餐酒店宿舍高工资
图片尺寸1080x1439
永济市 中医医院 影像中心
图片尺寸4032x3024
视源股份(cvte)2019届春季校园招聘正式启动
图片尺寸2167x1585
2017 cvte春招,与你一起创见未来
图片尺寸476x357
cvte视源股份
图片尺寸1200x933
cvte视源股份上榜《粤港澳大湾区企业专利创新百强榜》
图片尺寸1080x829
cvte视源股份中央研究院夺冠天池大数据竞赛
图片尺寸1927x1084
男子通过psg设备和数据监测提升睡眠质量(来源:tcci)
图片尺寸1400x933
参观视源cvte,一家自下而上驱动的企业
图片尺寸960x1280
cvp相关的那些事儿
图片尺寸960x1280
厉害了全市第一台spectct在湘潭市中心医院投入使用
图片尺寸6720x4480
病理性近视cnv的定义及治疗的新进展总结 (转载)
图片尺寸466x610
cvte暑期offer
图片尺寸1080x1439
cvte专注的六大行业领域 布局未来产业方向
图片尺寸600x400
每周最佳病例分享 | 从一个cnv说起
图片尺寸1055x703
聆听每颗心在cvte服务有问题我们找400
图片尺寸1209x681